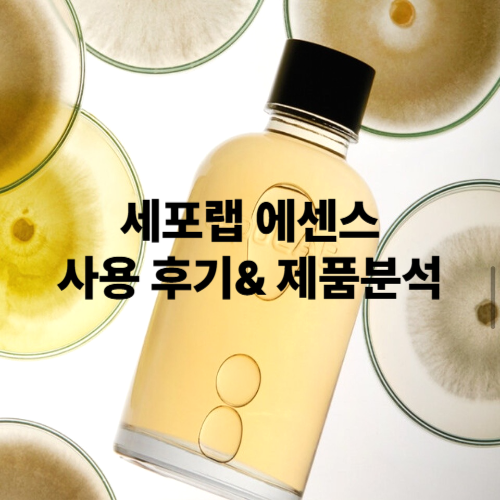
세포랩 에센스: 2년째 쓰는 솔직 후기 &amp; 제품 분석

40대 이후 피부는 속 당김, 탄력 저하, 칙칙함 같은 변화를 피할 수 없습니다. 이럴 때 가장 중요한 건 단순한 보습이 아닌, 피부 본연의 힘을 회복해 주는 케어인데요. 이는 세포랩 바이오제닉 에센스를 추천하는 이유입니다.
사실 2년째 사용하고 있는 제품이라 자신 있게 추천드릴 수 있어요. 오늘은 세포랩 에센스 후기와 함께 제품에 대해 상세히 알려드릴게요.
목차
1. 세포랩 에센스는 어떤 제품인가요?
세포랩 에센스는 피부의 세포 단위 회복을 목표로 한 고기능성 에센스입니다. 퓨젠바이오 연구진들이 균사체 연구 중 신물질 세리포리아 락세라타가 피부 밝아지고 개선되는 데 효과가 있다는 것을 발견하고 약 10년 동안의 연구 끝에 특허 성분 CLEPS®(클렙스)를 개발했습니다.
미생물이 생성한 대사 물질인 클랩스는 모공을 통해 피부 깊숙이 전달됨으로써, 피부의 3대 요소인 수분, 탄력, 회복력을 높이는 역할을 하게 됩니다. 노화 신호에 대응하여 젊은 피부로 유지하게 되는 거죠. 이런 순수 물질이 90% 이상 함유되어 있으니 얼마나 효과가 좋을까요?
▶ 진짜 성분, 단 5가지
| 성분명 | 기능 |
| CLEPS® 92.8% | 피부 본연의 활력을 살리는 핵심 바이오 성분 (특허 출원 성분) |
| 부틸렌글라이콜 | 수분 전달 및 제형 안정화 |
| 1,2-헥산다이올 | 보습 + 항균 안정화 |
| 하이드록시아세토페논 | 피부 진정 기능 |
| 소듐하이알루로네이트 | 히알루론산 보습 성분 |
✔ 인공 색소 없음
✔ 인공 향료 없음
✔ EWG 그린 등급 원료 사용
✔ CLEPS® 함량 92.8%로 타 브랜드 대비 압도적
상세한 정보는 세포랩 홈페이지에서 바로 확인해 보세요!

2. 세포랩 에센스 2년간 써보니 이런 변화가?
1️⃣ 속건조 완전 개선
나이가 들면서 건성 피부로 바뀌었는데, 언제부터인가 가을·겨울에 따로 크림을 덧바르지 않아도 건조함을 느끼지 않게 되었어요..
속 당김이 사라지니 피부 장벽도 훨씬 안정돼요. 에센스는 세안 후에 두 번 이상 톡톡 두드려 흡수시키며 사용했어요. 세면대 위에는 항상 세포랩 에센스가 놓여 있습니다.
2️⃣ 피부결 정돈
트러블이 거의 없었지만, 요철이 줄고 매끈한 느낌이 듭니다.
‘피부가 좋아 보인다’는 말을 자주 듣게 되었어요.
3️⃣ 자연스러운 톤 개선
미백 기능성은 아니지만, 피부결 + 보습이 개선되니 자연스럽게 밝고 정돈된 느낌이 들어요. 피부가 맑아진다는 표현이 더 맞을 것 같네요. 40대에 화사하다는 말을 자주 듣게 되는 비결입니다^^ 지금은 세포랩 에센스가 필수품이에요.
더 많은 후기와 상세한 정보는 세포랩 홈페이지에서 바로 확인해 보세요!



⚠️ 향은 조금 호불호 있을 수 있어요
향료가 전혀 들어 있지 않기 때문에, 처음엔 ‘무향’이라기보단 성분 고유의 자연 향이 납니다.
하지만 진짜로 자극 제로의 제품을 원하신다면 이건 오히려 장점이에요.
3. 가족 모두 함께 쓰는 안심 에센스
딸, 남편까지 모두 사용 중입니다.
민감한 피부나 10대 피부에도 순하게 작용하고,
남성분들도 끈적임 없이 흡수되어 면도 후 진정용으로도 좋다고 해요.
솔직하게 말하자면 저는 제품이 떨어지기 전에 미리 재구매하는 편이에요.
▶ 가격 및 구매 정보
| 용량 | 30ml | 155ml |
|---|---|---|
| 정가 | 26,000원 | 129,000원 |
| 비고 | 휴대용/ 입문용 | 대용량/ CLEPS® 고함량 |
| 공식몰 혜택 | 신규 가입 시 쿠폰 행사 및 할인 혜택 | |
※ 참고로 세포랩 에센스는 과대 포장 없이 심플한 유리 용기를 사용하는 것도 칭찬할 점입니다.
세포랩 : 브랜드스토어
이제 피부는 스스로 건강해질 거예요. 피부도 세포니까, 세포랩
brand.naver.com
4. 이런 분들께 진심으로 추천합니다
- ❄ 겨울철 속 당김이 심한 건성 피부
- 🔄 성분 하나하나 꼼꼼하게 따지는 소비자
- 👩👧👦 가족 모두 안심하고 쓸 수 있는 에센스를 찾는 분
- 🧬 피부 본연의 회복력을 믿는 분
- 🚫 인공 향·색소 없는 진짜 '미니멀 스킨케어'를 원하시는 분
'미용&건강' 카테고리의 다른 글
| 니파바이러스, 2025년 신종 감염병 한국 유입 가능성과 위험 요인 5가지 (0) | 2025.06.02 |
|---|---|
| “코로나 재유행 이미 시작됐다?” 여름휴가 앞두고 무서운 속도로 번지는 이유 [국내외 상황 총정리] (1) | 2025.05.30 |
| 체지방 유산균 TOP3 비교|BNR17, CLA, 가르시니아 과학적 근거 분석 (0) | 2025.05.20 |
| 아침에 유산균 하나, 진짜 달라집니다 – 비에날씬 프로 실사용 후기 (0) | 2025.05.10 |
| 보약을 먹어야 한다면? 구전녹용 vs 농협안심녹용의 결정적 차이 (0) | 2025.05.06 |
| 비오틴 영양제 TOP3 비교 리뷰|탈모에 진짜 효과 있을까? 과학적 원리부터 후기까지 총정리 (1) | 2025.05.02 |
| 2025년 탈모 샴푸 추천 TOP 3 비교 : 성분, 후기, 효과까지 꼼꼼 비교 (0) | 2025.05.01 |
| 바르면 바로 톤 업! 피부 미백 톤업크림 추천 BEST 5 (후기&판매량 기준) (1) | 2025.04.20 |